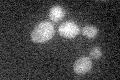
YDR527W
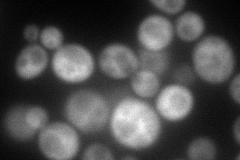
YDR527W
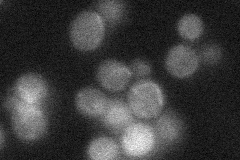
YDR527W
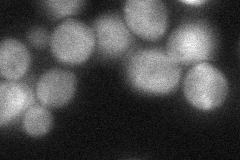
YDR527W
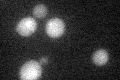
YDR527W

View description
Protein involved in transcription; interacts with RNA polymerase II subunits Rpb2p, Rpb3, and Rpb11p; has similarity to human RPAP1
Localization:
Intensity:
Fold change:
Significance:
-
C’ GFP library in SD
below threshold17.57 -
N' NOP1pr-GFP in SD

cytosol74.7523 -
N' TEF2pr-mCherry in SD
cytosol110.914 -
N' NATIVEpr-GFP in SD
cytosol25.8527 -
N' TEF2pr-VC and Cyto-VN in SD
cytosol44.4244 -
C’ GFP library in SD+DTT
cytosol16.060.91No -
C’ GFP library in SD+H2O2

cytosol17.060.97No -
C’ GFP library in Starvation Media

cytosol14.90.84No -
C’ GFP library on the background of Pup2-DaMP

below threshold -
C’ GFP library on the background of CCT mutant

below threshold18.24311.03776No
